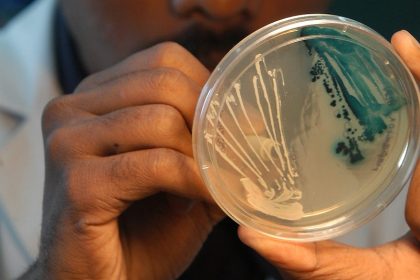

Étiquette : Enfants
Libye : Dépistage de santé au profit de 10 800 enfants
En Libye, plus de 10 800 enfants en milieu scolaire ont bénéficié…
Sierra Leone : Programme pour mettre fin au mariage des enfants
Le Fonds des Nations unies pour l'enfance (UNICEF) et le Fonds des…
En Afrique de l’Ouest, les enfants représentent plus de 60% des victimes de la traite
Ne laisser aucun enfant de côté dans la lutte contre la traite…
Éducation en situation d’urgence : Le Burkina actualise sa stratégie
Le Burkina Faso, où des milliers d’écoles sont fermées à cause de…
Aisha Ahmed Hussein : améliorer l’accès à une éducation de qualité pour les enfants somaliens
Pour de nombreux enfants en Somalie, aller à l'école et recevoir une…
Zambie : tous les enfants d’âge scolaire hors de l’école alors qu’une épidémie de choléra meurtrière tue plus de 500 personnes
Environ 4,3 millions d'enfants d'âge scolaire en Zambie - soit chaque enfant…
Soudan : une génération d’enfants est au bord du gouffre après 200 jours de guerre
Au 200e jour de la guerre brutale qui a éclaté au Soudan…
Cri d’alarme de l’Unicef : plus 8.000 enfants confrontés au choléra dans l’est de RDC
Plus de 8.000 enfants de moins de cinq ans ont été infectés…
Guerre au Soudan : plus d’un million d’enfants ont été déplacés (UNICEF)
Plus d'un million d'enfants, parmi lesquels 270.000 au Darfour, ont été contraints…
Somalie : 22 morts dont deux enfants dans la déflagration de munitions non explosées
Vingt-deux personnes, dont au moins deux enfants, ont été tuées dans la…
Nigeria : des hommes armés kidnappent 39 enfants dans une ferme
Un groupe criminel a enlevé 39 enfants travaillant dans une ferme dans…
Gambie : les autorités sanitaires soupçonnent un médicament après la mort de 28 enfants
Les autorités sanitaires gambiennes ont lancé une enquête sur la mort récente…